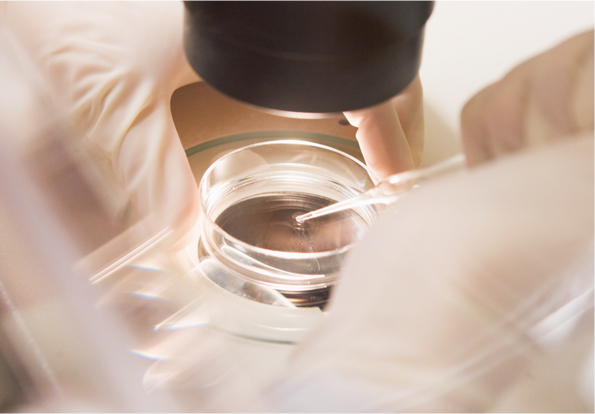

피부임상 연구소
피부를 연구하는 임상시험 연구기관으로
줄기세포배양액을 포함한
화장품 주요 성분의
보습, 미백, 탄력 등의 효용성과 피부 생리작용을 연구합니다.
피부임상 연구소
다양한 임상 연구 경험으로 효용성 검증을 위한
창의적이고 최적화된 연구 설계를 고집합니다.
화장품에 대한 진정한 가치를 세우고,
그 기대를 높여 화장품 산업의 발전에 기여합니다.
본 센터는 ‘생명윤리 및 안전에 관한 법률’을 엄격히 준수하여 모든 연구는
다산 IRB 위원회(DASAN Institutional Review Board)의 심의를 거쳐
진행하고 있으며 인간의 존엄과 가치를 준수하고, 생명윤리와 안전을 존중합니다.


화장품 주요 성분의
효용성 검증 연구
객관적이고 과학적인 근거를 바탕으로
화장품의 효용성 검증 연구


신원료, 신제형의
피부 생리 작용 연구
-
정밀한 피부측정 장비를 활용하여 화장품의
신원료 및 신제형이 피부에 미치는
생리 작용 연구 -


논문 게재 및 세미나 개최
국내외 학술지 논문
게재 및 피부 임상 연구
세미나 개최
산학협력 공동연구
시스템 운영
-
향장 분야의 석박사 연구자들과 더불어
산학협력 공동연구를 통한 학계 기여 -
제조문의 TOP

